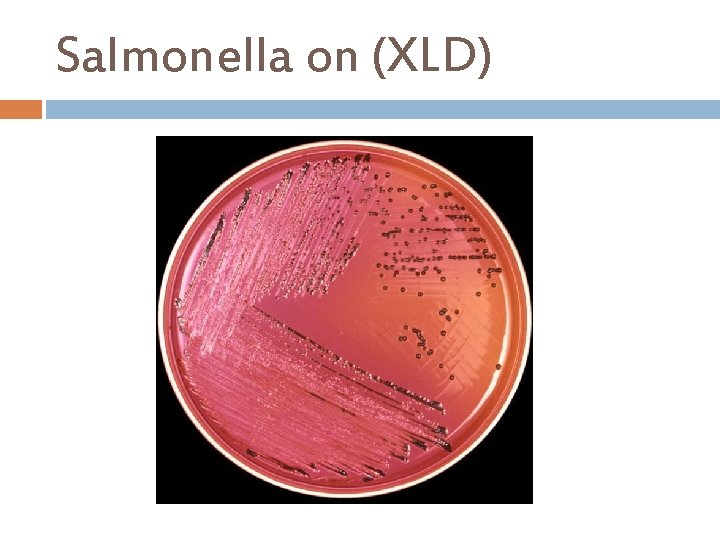
Salmonella on (XLD)
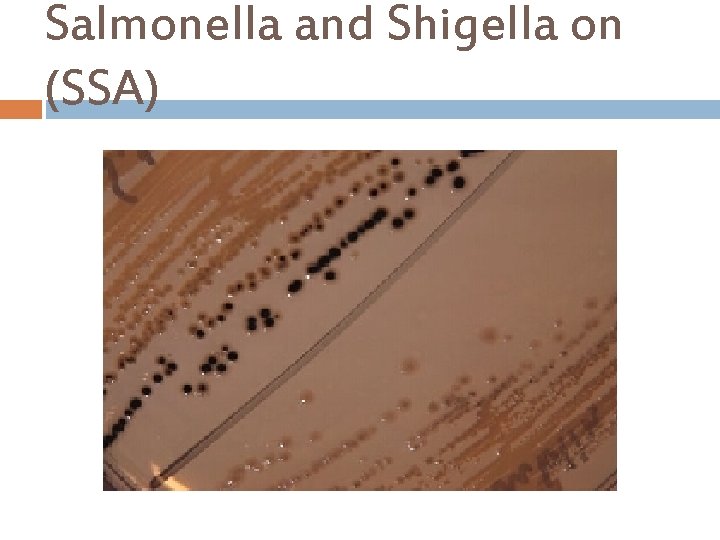
Salmonella and Shigella on (SSA)

ROUTINE STOOL CULTURE D M M Lab Routine

ROUTINE STOOL CULTURE D. M. M. Lab.

Routine Stool Culture Aim of the test Detect bacterial pathogenic organisms in the stool; only for Salmonella spp. or Shigella spp. Types of specimen Stool, rectal swab in fecal transport system or Duodenal or sigmoid aspirate. Who will collect the specimen The patient, If stool is unobtainable, nursing staff or physician will collect fecal swab or aspiration by physician. Quantity of specimen The specimen should contain at least 5 g of feces.

Gastrointestinal Tract Infections Common pathogens Commensals flora Salmonella spp. Enterobacteriaceae other than the common pathogens Bacteroides spp E. coli O 157: H 7 Streptococcus spp Staph aureus Lactobacilli Campylobacter spp. Yersinia enterocolitica Pseudomonas spp. Coagulase negative staphylococci Bacteroides Clostridium difficile Clostridium Shigella spp. Peptostreptococcus Bifidobacterium Eubacterium. Helicobacter pylori Vibrio cholerae

Specimen Collection and Handling I. Pass the stool into a clean, dry, plastic disposable container · II. DO NOT MIX URINE OR WATER WITH THE STOOL SPECIMEN. III. Formed or semi-formed stool: Use the spork provided in the cap of the vial to pick a portion of the stool equivalent to the size of a navy bean and MIX it into transport media in the vial. Any blood or mucous should be included. IV. Liquid stool: Add approximately ½ to 1 teaspoon of fluid to the bottle and MIX into the transport media. DO NOT let the specimen sit on top of the media. V. Rectal swabs: Insert the swabs into the transport media. VI. Tighten cap completely. A leaking specimen unsuitable for testing. VII. Clean the outside of the vial with rubbing alcohol or soap and water if it is soiled. VIII. Check to make sure the patient name and date of collection are still readable.

Specimen Collection and Handling continue…. . Collection Specimen Stool Routine culture Guidelines Device and or minimum Transport Storage vol. Pass directly into clean Sterile, leak dry container. proof, wide. Transport to mouth microbiology laboratory container within 1 h of collection. Criteria of specimen rejection Time and Temp Unpreserve ≤ 24 h, , 4ċ d ≤ 2 h, RT specimen contaminated with urine, residual soap, or disinfectants. Specimens received in grossly leaking transport containers, Diapers, dry specimens submitted in fixative or additives.

Specimen Processing

Xylose lysine Deoxycholate (XLD) A selective and differential medium for the recovery of Salmonella and Shigella species. Ingredients : Lactose. . . . . 0. 75 % Sodium Chloride Sucrose. . . . . 0. 75% Yeast Extract Xylose. . . . . 0. 35% Sodium Deoxycholate L-Lysine. . . . . 0. 5% Ferric Ammonium Citrate Agar. . . 1. 35 Sodium Thiosulfate % Phenol Red Final p. H 7. 4 ± 0. 2 at 25°C

Xylose lysine Deoxycholate (XLD) Principle. . . Sodium desoxycholate inhibits contaminating Gram-positive flora. Xylose is fermented by practically all coliforms bacteria and Salmonella, except for Shigella which are thus differentiated from the other species. After exhausting xylose, Salmonella decarboxylate lysine (via lysine decarboxylase) to cadaverine, causing the p. H to rise. Colonies of Salmonellae resemble those of Shigellae in the medium having become basic. Phenol red is the p. H indicator. The addition of lactose and sucrose to the medium enable coliform bacteria to decarboxylate lysine and thereby produce excess acidity, making the indicator turn yellow, favoring their differentiation. Sodium thiosulfate and Ferric the detection of the H 2 S producing bacteria. ammonium citrate allow
Salmonella on (XLD)

Salmonella-Shigella Agar(SSA) This agar is for isolating Salmonella & Shigella species, These are the type of infectious organisms that are recovered from stool specimens. Ingredients : Beef Extract Pancreatic Digest of Casein Peptic Digest of Animal Tissue Lactose. . . . 1% Brilliant Green Bile Salts Sodium Citrate Sodium Thiosulfate Agar. . . 1. 35% Ferric Citrate Neutral Red Final p. H 7. 0 ± 0. 2 at 25°C

Salmonella-Shigella Agar(SSA) Principle… There are four main ingredients in this agar: i. Lactose – to show lactose fermenters or non-lactose fermenters. ii. Bile Salts, Sodium Citrate and Brilliant Green- inhibit Gram-positive bacteria, most coliform bacteria. iii. Sodium thiosulfate and Ferric citrate allow the detection of the H 2 S producing bacteria such as Proteus and some strains of Salmonella, as they produce colonies with black centers iv. Neutral Red is the p. H indicator. E. coli & Klebsiella pneumoniae are two gram negative organisms that will ferment the lactose and exhibit reddish/pink colonies on this agar. Salmonella & Shigella species are non-lactose fermenters that will not produce any color on this media, so they will look like they are colorless. Salmonella will be the organism that will produce Hydrogen Sulfide in the middle of the colony it produces on this agar.
Salmonella and Shigella on (SSA)

Hektoen Enteric Agar (HEA) Hektoen Enteric Agar is used for the isolation and cultivation of gramnegative enteric microorganisms, especially salmonella and shigella. Ingredients : Beef Extract Pancreatic Digest of Casein Peptic Digest of Animal Tissue Lactose. . . . 1. 2% Bile Salts Sucrose. . . . 1. 2% Sodium Chloride Salicin. . . . . 0. 2% Agar. . . 1. 35% Bromthymol Blue Final p. H 7. 5 ± 0. 2 at 25°C Acid Fuchsin Sodium Thiosulfate Ferric Citrate

Hektoen Enteric Agar (HEA) Principle… Bile Salts and Acid Fuchsin inhibit Gram-positive organisms. Lactose, Sucrose, and Salicin are fermentable carbohydrates. Ferric Ammonium Citrate, a source of iron, allows production of hydrogen sulfide (H 2 S) present from Sodium Thiosulfate. H 2 Spositive colonies have black centers. Bromothymol Blue and Acid Fuchsin are added as the p. H indicator. The indicator bromothymol blue changes its color to yellow and acid fuchsin would changes color from yellow to orange- red when acid is formed. Appearance of Colonies Microorganisms Green, moist, flat, transparent Shigella, Providencia Blue-green, with or without a black centre Salmonella, Proteus Green to bluish, flat, irregular edge Pseudomonas Orange-red surrounded by a zone of precipitate. Coliform bacteria

Shigella and Coliforms on (HEA)

Salmonella and Shigella on (HEA)

Selenite F broth is an enrichment medium for the isolation of salmonella species and some shigella species from faecal or urine specimens. Ingredients : Sodium hydrogen Selenite Peptone Final p. H 7. 0 ± 0. 2 at 25°C Lactose Disodium hydrogen phosphate sodium dihydrogen phosphate Sodium Selenite inhibits the growth of Gram-positive bacteria and many Gram-negative bacteria, whereas the salmonellae are not affected. Sodium selenite is highly toxic at near-neutral p. H. Buffer salts are present to help maintain the p. H which may rise as the toxicity decreases . A rise in p. H decreases selective activity of Selenite. A fermentable carbohydrate ( lactose) is also present to provide acid to

Additional Information Notes In enteric fever caused by Salmonella typhi, S. choleraesuis, or S. enteritidis, blood culture may be positive before stool cultures, and blood cultures are indicated early; urine cultures may also be helpful. Stool samples should be examined and cultured as soon as possible after collection. As the stool specimen cools, the drop in p. H will inhibit the growth of most Shigella spp. and some Salmonella spp. Gram Negative (GN) broth is selective enrichment medium used for the cultivation of enteric pathogens including shigella and salmonella It is especially useful when the salmonella or shigella are present in low numbers.

Additional Information continue…. . Tetrathionate Broth, with added iodine-iodide solution, is used as a selective enrichment medium for the isolation of Salmonella. Stool culture received for routine culture in some laboratory in Palestine should be examined For the presence of Salmonella, and Shigella spp. One gram of stool is transported to tube of selenite F broth and a loop is streak on at least two of stool cultures media, ( we recommended both HEA and XLD to be used, because SSA may inhibit some strains of salmonella or shigella) and incubated at 37ċ, after the overnight incubation subculture from selenite F broth onto a fresh plate of XLD and HEA at least. For un routine culture the physician must specify in the request. Campylobacter spp. Is routine as salmonella and shigella but in Palestine is un routine and Can isolate on campy blood agar plate media, one single stool specimen can not be used to rule out bacteria as a cause of diarrhea, plates should be incubated in a microaerophilic atmosphere at 42ċ and examined at 24 -48 hours for suspicious colonies.

Post Specimen Processing Interfering factors: Patient on antibiotic therapy. Improper sample collection. Result reporting: A positive report will be issued only in case salmonella or shigella were isolated, otherwise, a negative report will be issued. Turn around time: Isolation of a possible pathogen can be expected after 2 -4 days. Negative culture will be reported out 2 days after the receipt of the specimen as No Enteric Pathogens Isolated.

STOOL CULTURE, VIBRIO COLERAE D. M. M. Lab.

Stool Culture, Vibrio cholera Aim of the test To isolate Vibrio cholera from stool specimen and perform antibiotic sensitivity testing. Pre-Specimen processing See under stool culture, routine. ( Rice water stool ). Specimen processing Media I. II. Alkaline peptone water. TCBS (Thiosulfate Citrate Bile salt Sucrose Agar).

Specimen Processing Pick typical yellow colonies from TCBS Agar and perform API 20 E SYSTEM

Thiosulfate Citrate Bile salt Sucrose (TCBS )Agar Thiosulfate-Citrate-bile Salts-Sucrose agar or TCBS agar is a type of selective agar culture plate that is used in microbiology labs to isolate Vibrio spp. , Vibrios grow well at 35 -37°C on media containing one percent sodium chloride and a very high p. H (8. 5 -9. 5). Halophilic vibrios require sodium chloride for optimum growth and metabolic activity. Ingredients : Yeast Extract Peptone Sucrose Sodium Thiosulfate Soium Citrate Bromthymol Blue Agar. . . . 1. 5% Thymol Blue Final p. H 8. 6 ± 0. 2 at 25°C Sodium Chloride. . . 1. 0% Ferric Citrate Bile salts

Thiosulfate Citrate Bile salt Sucrose (TCBS )Agar Principle : TCBS Agar contains a complementary source of plant and animal One percent Sodium Chloride, Sodium thiosulphate source of sulfur (in combination with Ferric citrate, detects hydrogen sulphide production). , and yeast extract, all proteins, of which allow optimum growth. The Bile Salts in the media inhibit the growth of gram-positive microbes. The presence of Sucrose allows for the differentiation of those vibrios, which can utilize sucrose with the aid of Bromthymol blue, and Thymol blue p. H indicators. The high p. H ( 8. 6 p. H )of TCBS Agar suppresses other intestinal

(TCBS Agar p. H indicators)

Vibrio cholerae on (TCBS) Agar V. cholerae. . . . Large yellow colonies

Alkaline Peptone Water is used for the enrichment of Vibrio cholera and Vibrio species from food, water, feces and clinical studies. Clinical materials containing small numbers of Vibrio should be inoculated into an enrichment medium prior to plating onto a selective medium, such as TCBS Agar. Ingredients : Peptone Sodium Chloride. . . 1. 0% Final p. H 8. 6 ± 0. 2 at 25ºC

Alkaline Peptone Water Principle: Alkaline Peptone Water is a suitable enrichment broth for Vibrios. The relatively high p. H of the medium (approximately 8. 6) provides a favorable environment for the growth of vibrios. It is claimed that raising the medium’s p. H leads the medium’s alkalinity to inhibit most of the unwanted flora background, leaving the viability of the Vibrio species intact. Growth in tubes is indicated by turbidity compared to an uninoculated control. • Additional steps are recommended, like plating onto a selective and nonselective media for isolation and morphology, and biochemical and serological studies for identification.

Post Specimen Processing Interfering factors: Patient on antibiotic therapy. Improper sample collection. Result reporting: A positive report will be issued only in case Vibrio cholera isolated, otherwise, a negative report will be issued. Turn around time: were Isolation of a possible pathogen can be expected after 4 -5 days. Negative culture will be reported out 2 -3 days after the receipt of the specimen.

STOOL CULTURE, E. COLI O 157: H 7 D. M. M. Lab.

Stool Culture, E. coli O 157: H 7 Aim of the test Detect E. coli O 157: H 7 from stool specimen or rectal swab and perform sensitivity test. The Latex test will demonstrate by slide agglutination, E. coli strains possessing the somatic O 157 antigen and Flagella H 7 antigen.

Specimen Processing

Sorbitol Mac. Conkey (SMAC) Agar This is a selective and differential medium for the isolation of Escherichia coli O 157: H 7. Ingredients : Casein peptone Sodium Chloride Meat peptone Crystal violet Sorbitol …………. 1. 0% Neutral red Agar. . . 1. 2 Bile salts % Final p. H 7. 4 ± 0. 2 at 25°C

Sorbitol Mac. Conkey (SMAC) Agar Principle… This medium contains Sorbitol instead of lactose and it is recommended for the detection of E. coli 0157: H 7 which ferments lactose but does not ferment Sorbitol and hence produce colorless to pale yellow colonies in the presence of Neutral red p. H indicator. Sorbitol fermenting strains of E. coli produce pink-red colonies, The red color is due to production of acid from sorbitol, in the presence of Neutral red p. H indicator which change into pink when the p. H of the medium drops below 6. 8. Crystal violet and Bile salts to inhibit It’s also contain gram positive bacteria.

Sorbitol Mac. Conkey (SMAC) Agar

Sorbitol Mac. Conkey (SMAC) Agar Escherichia coli O 157: H 7 colonies growing on Mac. Conkey Agar with Sorbitol Incubated aerobically for 24 hours at 37 deg. C. Escherichia coli colonies growing on Mac. Conkey Agar with Sorbitol Incubated aerobically for 24 hours at 37 deg. C.

E. coli O 157 LATEX TEST Principle of the Test Procedure: Latex particles are coated with an antiserum against E. coli O 157 antigen. When the coated latex particles are mixed with fresh colonies of E. coli serotype O 157 the bacteria will bind to the antiserum, causing the latex particles to visibly agglutinate (positive reaction). Bacteria which are not O 157 serotype will not bind to the antiserum and will not result in agglutination (negative reaction). Test Procedure: Allow all reagents to come to room temperature before use. The E. coli O 157 Latex Reagent and Negative Control Latex Reagent must be tested with the Positive Control Antigen prior to running test specimens. The E. coli O 157 Latex Reagent must show positive agglutination and the Negative Control Latex Reagent must show no agglutination within two minutes. This indicates that the reagents retain their activity.

Test Procedure 1. Test material may be obtained by culturing clinical specimens and using either: a) Non-sorbitol fermenting colonies (NSFC) from Sorbitol Mac. Conkey agar medium. b) Subculture of NSFC from non-selective agar medium. 2. Select suitable colonies from the agar medium surface. 3. Re-suspend the colonies in 0. 2 ml normal saline in a culture tube. 4. Place one drop of E. coli O 157 Latex Reagent on to a test circle on one of the test cards provided. Using a sterile pasteur pipette add one drop of the test specimen (colony suspension) to the test circle, then mix with the Latex Reagent using one of the mixing sticks provided.

Test Procedure continue …… 5. Rock the card gently and examine for agglutination for up to two minutes. 6. Isolates that give a positive result with the test latex must be tested further by repeating the procedure using the Negative Control Latex Reagent.

Quality Control The E. coli O 157 Latex Reagent and Negative Control Latex Reagent must be tested with the Positive Control before running the test isolates. There must be agglutination with the E. coli O 157 Latex Reagent within two minutes and no agglutination with the Negative Control Latex Reagent latex particles coated with purified rabbit Ig. G that reacts with E. coli serogroup O 157. Latex particles. Positive Control suspension containing E. coli serotype O 157: H 7 antigen. Negative Control latex particles coated with purified rabbit Ig. G that does not react with E. coli serogroup O 157.

Interpretation of the Results 1. The following table shows how the results obtained with the E. coli O 157 Latex Reagents and the E. coli O 157 Positive Control should be interpreted:

Interpretation of the Results 2. Agglutination of latex reagents with test specimen is interpreted as shown below:


Post Specimen Processing Interfering factors: Patient on antibiotic therapy. Improper sample collection. Result reporting: A positive report will be issued only in case E. coli O 157: H 7 were isolated, otherwise, a negative report will be issued. Turn around time: Isolation of a possible pathogen can be expected after 2 -4 days. Negative culture will be reported out 2 days after the receipt of the specimen.
- Slides: 45